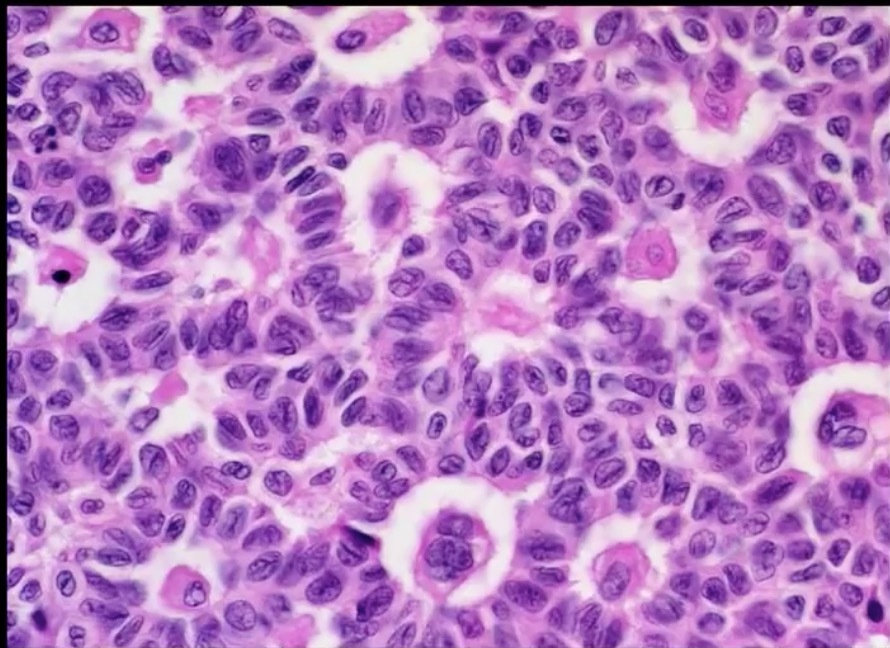
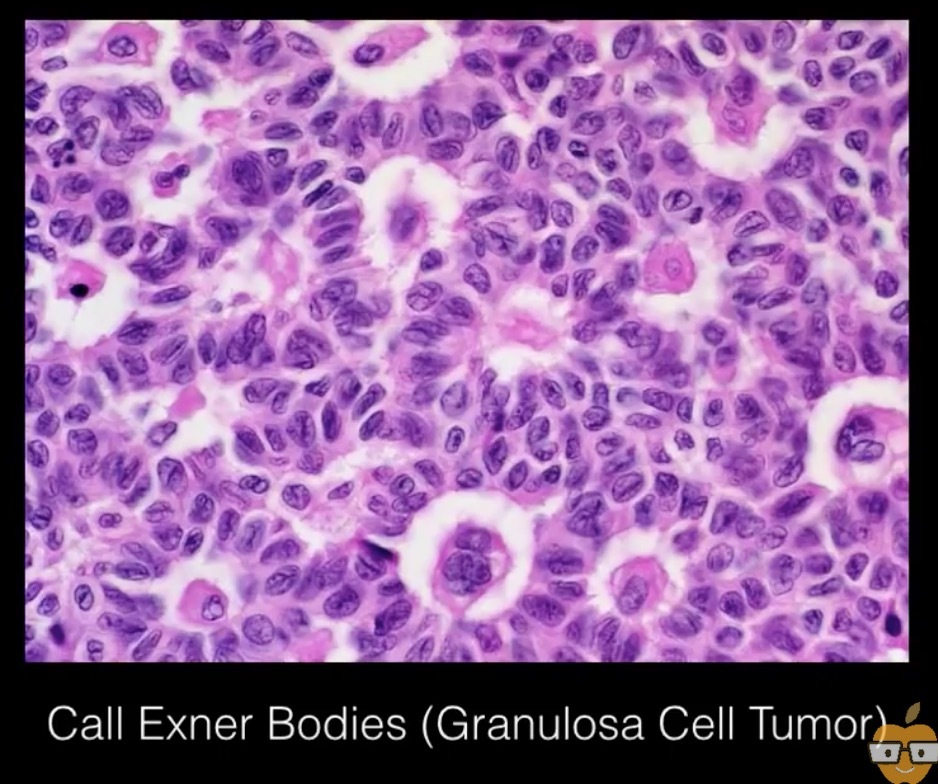
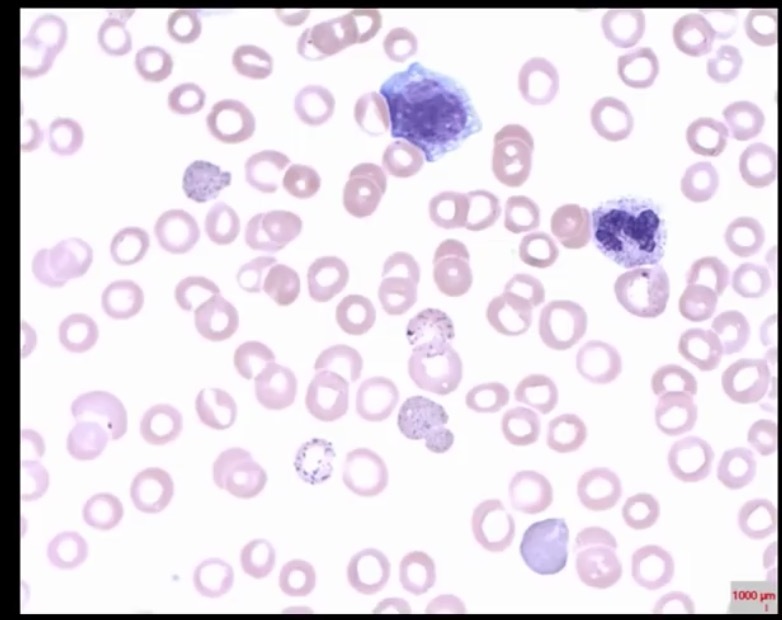
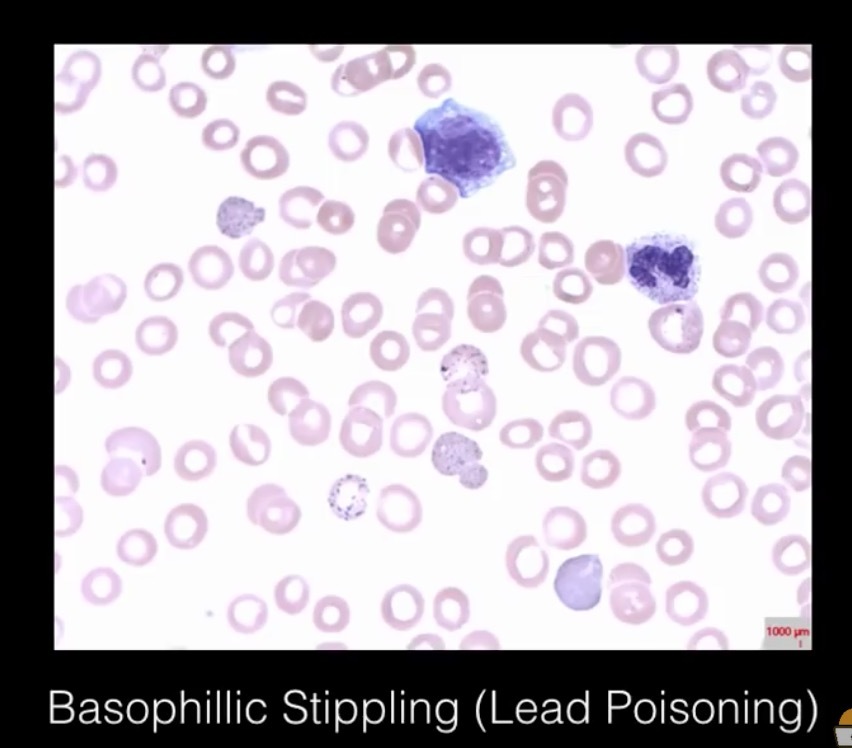
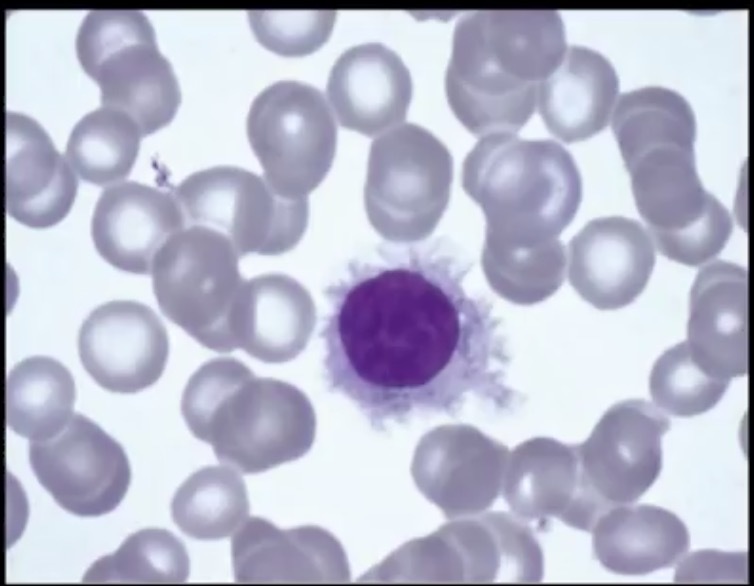
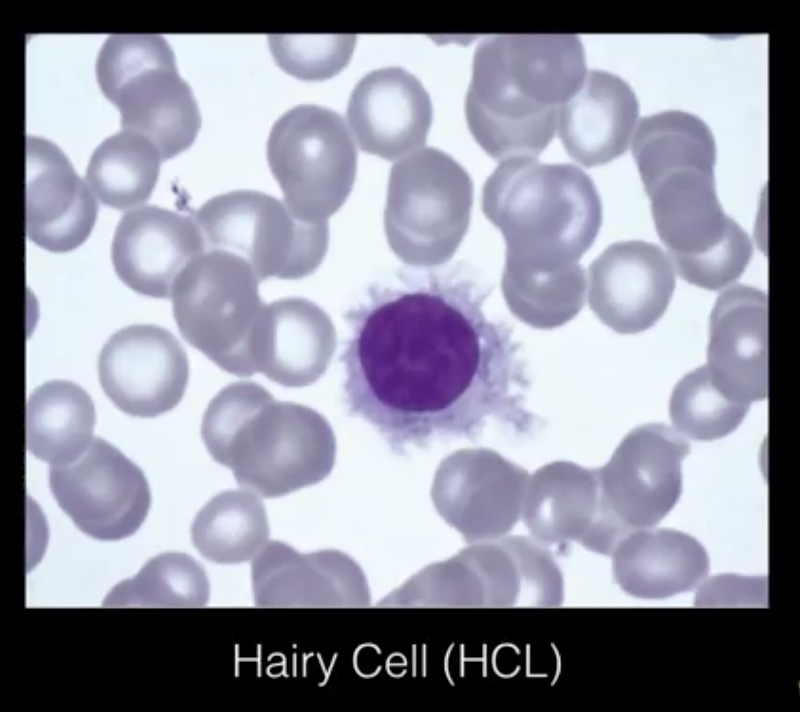
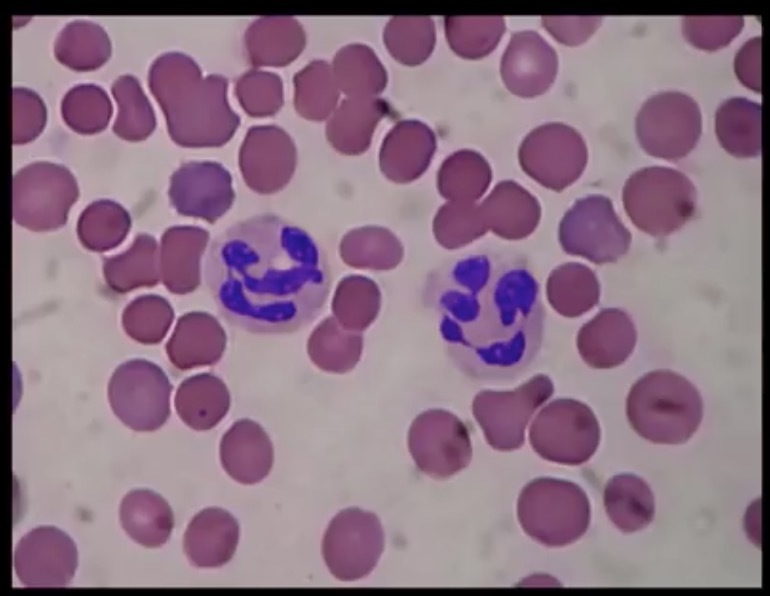
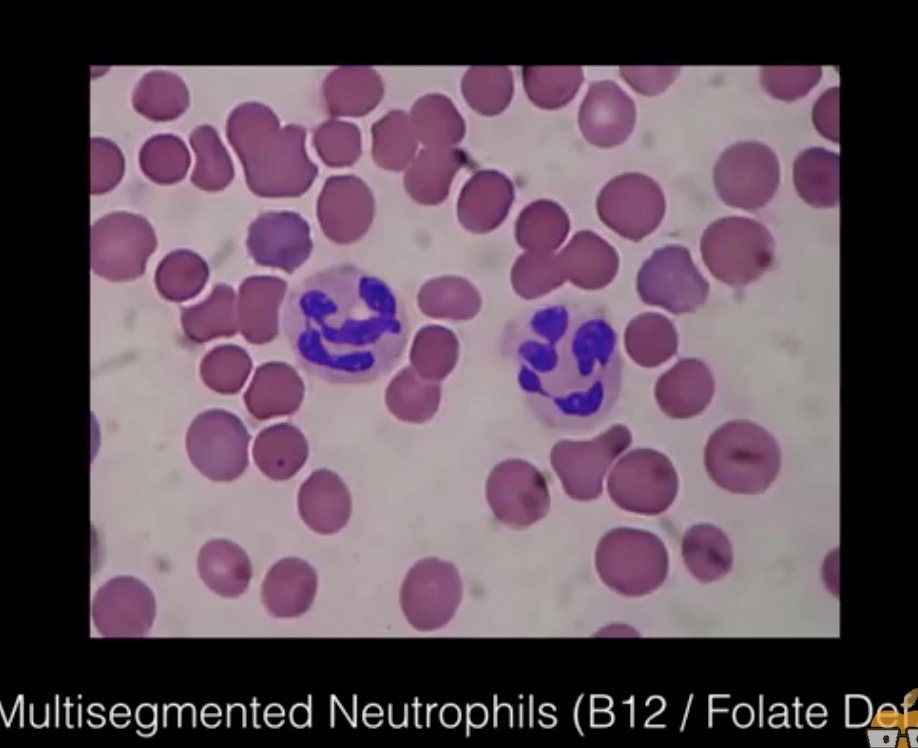

1
Q

A
Clue cells
Garnerella vaginosis
2
Q

A

3
Q
A
4
Q

A

5
Q

A

6
Q
A
7
Q

A

8
Q

A

9
Q
A
10
Q

A

11
Q
A
12
Q

A

13
Q

A

14
Q

A

15
Q

A

16
Q

A

17
Q

A
Homer-Wright Rosettes
Neuroblastoma
18
Q

A
Candida infect
Esophagitis
19
Q

A
Gastric cancer
Signet ring cells
- Diffuse type (not h. pylori)
20
Q

A
Alcoholic hpeatitis
Mallory bodies
(intracytoplasmic eosinophilic inclusions of damaged keratin filaments)
21
Q

A
Alpha1- Antitrypsin deficiency
Cirrhossi with PAS positive globules in liver

22
Q

A
Hemochromatosis
Hemosiderin (iron) identified on liver mRI or biopsy with Prussian blue stain

23
Q

A
Reed Sternberg
Hodgkin lymphoma
24
Q

A
Starry sky
Burkitt lymphoma (8;14) c-myc
25

Call- Exner bodies
Granulosa cell tumor of ovary

26

Schiller-Duval vodies (resemble glomeruli)
Yolk Sac tumor

27


